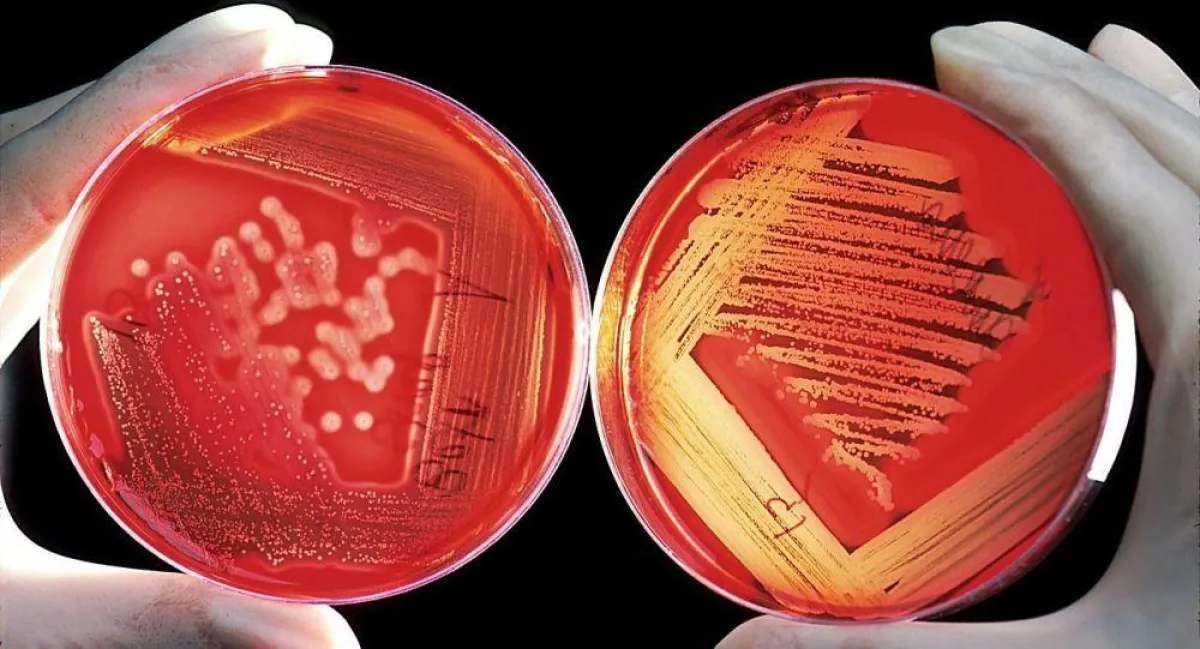

بعد معاناةٍ كبيرةٍ مع مرض ٍ نادرٍ ، كاد يودي بحياته .. تمكن أطباء من إنقاذ رجلٍ ألمانيٍ، تحول دمه من اللون الأحمر إلى الأبيض.بعد أن استعانوا بطريقةٍ قديمةٍ ، تم ابتكارها منذ آلاف السنين، تعرف باسم "الفصد".إثر الفشل المتكرر لطريقة العلاج الحديثة .
وكان الرجل 39 عاماً مهدداً بالموت، عقب تكوين جزيئات دهنية تسمى الدهون الثلاثية في الدم، وعادة ما يعالج الأطباء هذه الحالة بتقنية تسمى البلازما.
وتعتمد التقنية وفقا لموقع "لايف ساينس".على استخراج بلازما الدم من الجسم، وإزالة الدهون الثلاثية الزائدة وأي مكونات سامة أخرى، قبل إعادة الدم النظيف إلى المريض.
وعادة ما يكون المستوى الطبيعي للدهون الثلاثية في دم الشخص أقل من 150 ملغ / ديسيلتر، وتكون القراءة مرتفعة عندما تتراوح ما بين 200 إلى 499 ملغ / ديسيلتر، فيما تعتبر 500 ملغ/ ديسيلتر "عالية جدا".
ولكن في الحالة النادرة للرجل، بلغ مستوى الدهون الثلاثية 36 مرة أعلى من المعدل الذي يعد عادة "عاليا جدا"، حيث بلغ نحو 18000 ملغ/ديسيلتر.
تابعي أيضاً: فاجعة.. غرق أسرة كاملة بينهم 5 أطفال في ترعة بصعيد مصر
وأشار الأطباء إلى أن هذا هو السبب وراء إصابة الرجل بالغثيان والقيء والصداع والتدهور الصحي عندما وصل المستشفى.
وأوضح الأطباء أن إصابة الرجل بهذه الحالة يعود إلى العديد من العوامل ذات الصلة المتعلقة بالسمنة والنظام الغذائي ومقاومة الإنسولين والاستعداد الوراثي المحتمل.
ومع فشل طريق العلاج الحديثة في علاج الحالة، استعان الأطباء بطريقة تم ابتكارها منذ آلاف السنين، تعرف باسم "الفصد".
وتعتمد التقنية القديمة على إخراج الدم من أحد أجزاء الجسم عن طريق إحداث شق في وريد رئيسي، وهي طريقة تعود إلى مصر القديمة منذ نحو 3 آلاف عام.
وقام الأطباء بسحب لترين من دم المريض، واستبداله بمركز من خلايا الدم الحمراء والبلازما المجمدة النقية، ومحلول ملحي فسيولوجي.
وبهذه الطريقة تمكن الفريق الطبي من خفض مستويات الدهون الثلاثية للمريض، وبحلول اليوم الخامس بعد إجراء العملية استقرت حالة الرجل.

Google News
Google News 

















